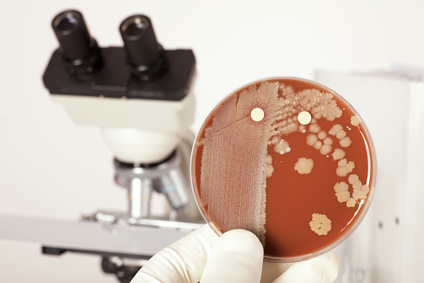

Nutztierpraxis
Rinder
Labordiagnostik
Blutproben
Wir haben in unserer Praxis die Möglichkeit wichtige Parameter wie Leberwerte, Calcium und Muskelenzyme zu untersuchen. Für weitere Untersuchungen wie Stoffwechselprofile, Fruchtbarkeitsprofile etc. arbeiten wir mit einem Speziallabor zusammen, welches die Proben schnell und unkompliziert untersucht. Die Ergebnisse bekommen wir in der Regel innerhalb von 24 Stunden per Fax oder Mail übermittelt.
Milchproben
nnerhalb von 24 Stunden können wir in der Praxis einen Resistenztest
durchführen, so dass sie bereits am nächsten Tag wissen, welche
Medikamente bei einer Euterentzündung am besten wirken. Sollte ein Erregernachweis gewünscht werden, so leiten wir die Proben an das MBFG weiter.
Des
weiteren können wir einen Hemmstofftest durchführen, um zu untersuchen,
ob Milch wieder lieferbar ist. Dieser dauert etwa 3 Stunden.

Kotproben
Für Durchfall bei Kälbern haben wir einen Schnelltest mit dem wir die
vier wichtigsten Erreger E. coli, Cryptosporidien, Rota- und Coronaviren
nachweisen können.
Des Weiteren können wir über eine Flotation
Parasiten im Kot nachweisen. Sollte eine weitere Diagnostik erforderlich
sein, so leiten wir die Proben an das Landeslabor weiter.
